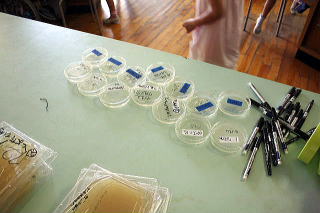

|
| 平成24年度 第5回竜之口サイエンスラボ |
| 「手洗いってほんとうに必要?」 〜みのまわりの菌をつかまえろ〜 |
| 平成24年7月27,31日 |
| 指導 後川 |
| 身の回りに沢山の菌がいることとを実感し、菌が増えると眼に見えるコロニーを形成することを実感することを目的とし、手を洗うこと、消毒することの意味を理解し、その効果を実感することを目指す。 |
 |
| ○ 班分け。班で自己紹介。→班長、副班長を決める。 ○ 副班長は実験データシートを前に撮りに来る。※副班長が実験データは記入する。 |
 |
 |
| 菌はどんな形をしているかな | |
 |
 |
| 菌はどんなとこにいるかな | |
 |
 |
| ロウションを付けBB(black light)で手の汚れを見る。 | 手形寒天培地に10秒くらい手を載せすぐ蓋を閉める |
|
 |
 |
 |
| 菌が居そうな場所を列挙 | 手を洗ったあと手形寒天培地に 10秒くらい手を載せすぐ蓋を閉める |
 |
 |
| 3日後の手形寒天培地 | 結果をスケッチ |
| 低学年での講座の流れ |
| ○ 菌について説明を聞く (Power Point 使用.) 1.. 菌の形、色、大きさについて説明。 (1) 菌の形、色、大きさを想像する。 (2) 各児童が自分のプリントに想像の「菌」の絵を描く。 (3) 班長は、みんなが一番いいと思う菌の形を決める。 (4) 決まったら、その菌を書いた児童が出て、黒板に書く。 2. 菌の性質、働きについて説明。 3. 見えない菌を見えるようにするための条件や方法の説明。 4. 菌はどこに居るだろうかと、問題提起 実験Iへ |
| 実験I 「どんなところに菌はうようよしているだろうか?」 (1) 菌がたくさん居そうな場所(理科室周辺で)を班のみんなで考える。 (2) 場所が決まったら、副班長はその場所を黒板とデータシーtに記入する。 (3) (2)と同時に班長は寒天培地の入ったシャーレの蓋に班の番号を書き、班員2,3人で その場所にシャーレを置きに行く。 必ずシャーレの蓋を開ける。 |
| 実験II 「どんなものに菌がたくさんついているかな。いないかな。」 (1) 身の回り、学校の周りにあるもので、「菌」がいっぱい付いていそうな物(A)と、 「菌」があまり付いてなさそうな物(B)を班のみんなで考えて決める。 ※ 9cmのシャーレに入るものなら、石でも葉っぱでも消しゴムでも何でもOKです。 (2) 班長は班員1,2名と班で決めたサンプルAtoサンプルBを取りに行く。(10分以内) (3) (2)と同時進行で副班長と残りの班員は2つのシャーレの蓋の上に「サンプルの名前」、 「班番号」、「日付」を書く。副班長は黒板と実験データシートにも記入する。 (4) サンプルAを寒天培地1枚に10秒くらいくっつける(少し塗る感じでもOK) (5) サンプルBを寒天培地1枚に10秒くらいくっつける(少し塗る感じでもOK) (6) シャーレを前に提出する。 |
| ○ なぜ手洗いが必要かに付いての説明 (1) 「なぜてを洗わないといけないか」を問いかけ、数名に答えさせる。 (2) 「ばい菌」と「常在菌」に関する説明。 (3) 手洗いの必要性の説明(Power point 使用) |
| 実験III 「手にも本当に菌がすんでいるのかな」 (1) 各自、手形寒天培地(パームスタンプ)に10秒くらい手をのせ、すぐに蓋を閉める。 ※ 強く押し付けると寒天培地が割れます。割れても問題ありませんが観察しにくい。 (2) 手を洗いペーパータオルで拭く。 (3) 蓋に「日付」、「班番号」、「自分の名前」、「手洗い前」と記入する。 |
| 実験IV 「いつも手はきれいに洗えているのかな。手を洗うと菌は居なくなるのかな」 (1) 手にローションをのせてもらい、手のひら、手の甲、まんべんなく塗り広げる。 ※ ローションはスタッフにのせてあげるほうが良いと思います。 (2) ブラックライト(BL)に手をかざし、手が光っているのを確認する。 (3) 普段のやり方で手を洗う (4) もう一度BLに手をかざしてみる。光るところが無くなるまで、しっかり手を洗う。 (5) 班長と班員1,2人は、持ってきたハンカチで手を拭いて、もう一枚のパームスタンプに手をのせる。「日付」、「班番号」、「自分の名前」、「水洗い」と記入する。 (6) 手の洗い方の説明(Power point 使用) (7) 福班長と残りの班員はもう1回、今度はハンドソープをつけて手を洗う。 (8) 持ってきたハンカチで手を拭いて、もう1枚のパームスタンプに手をのせる。 「日付」、「班番号」、「自分の名前」、「石けん洗い」と記入する。 (9) 班長は実験Iで置きに行ったシャーレを取ってくる。 (10) 全部、前に提出する。 スタッフにお願い。 3日後の観察は全部蓋を開けずに行いますので、蓋のとめてないものは蓋があかないようにセロテープ等で何箇所かとめてください。 |
| 3日後の観察 (要約) |
| 実験I 「どんなところに菌はうようよしているだろうか?」 菌の塊(コロニー)の数を数えたり、色や形を調べたり、何種類あるか等調べノートの記入する。結果からどんなことが分かったかみんなで考える。班長が黒板で報告。 |
| 実験II 「どんなものに菌がたくさんついているかな。いないかな。」 前と同様の観察をし、自分たちの予想が当たったかどうか話し合う。班長が黒板で報告。 |
| 実験III 「手にも本当に菌がすんでいるのかな」 実験IV 「いつも手はきれいに洗えているのかな。手を洗うと菌は居なくなるのかな」 手洗い後のパームスタンプの様子をスケッチする。手洗いの結果から何が分かったか話し合う。各自感想をプリントに書く。班長と副班長がシャーレ、パームスタンプを袋に入れて提出、処理してもらう。 |